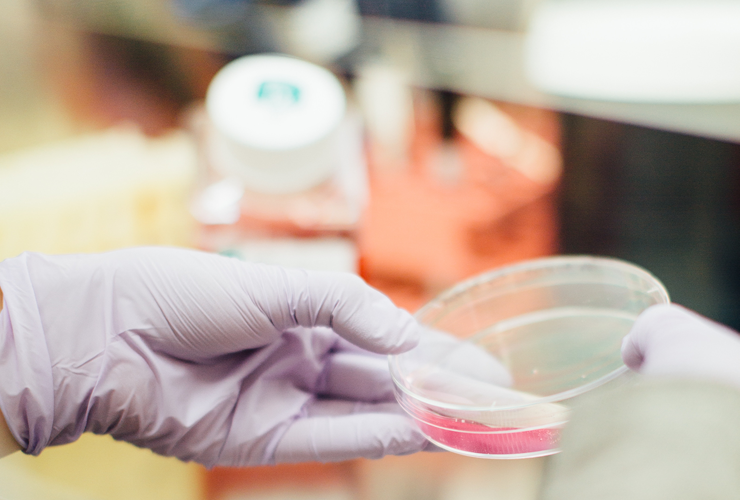
drug discovery hero

AI 2020: The future of drug discovery
Add bookmarkDrug development is set to enter a dynamic new era as intelligent enterprise technologies allow pharmaceutical companies to bypass many of the sky-high costs that can hinder and delay the research and development process, according to a new deep-dive study by Pharma IQ
Photo by Drew Hays on Unsplash
The report examines the role intelligent enterprise (IE) technologies—including AI, the internet of things (IoT), robotic process automation (RPA), machine learning and data analysis—will play within the future Pharma industry, looking at which providers are investing, which are not, and where opportunities might lie.
Almost 95% of the pharma professionals surveyed said they expected the impact of intelligent technological innovation to take hold in the wider drug development industry over the next three years. However, a lack of understanding and awareness about the benefits of AI-led technologies remain a hindrance to their implementation—40 per cent of companies have yet to start.
Almost 95 per cent of the pharma professionals surveyed expect the impact of intelligent technological innovation to take hold in the wider drug development industry over the next three years.
Concerns include organizations’ pressure to capture return on investment with these technologies and the inherent challenges involved in upgrading legacy systems.
The full report entitled ‘AI 2020: The future of drug discovery’ was produced by PharmaIQ in association with The AIIA Network.
The report is part of IQPC’s cross-sector market study on the adoption of IE technologies, which includes deep-dive analysis of the oil and gas, defence and customer experience sectors.
[inlinead]